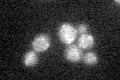
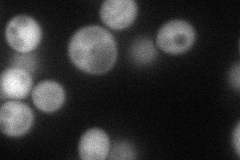
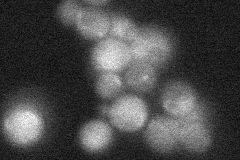
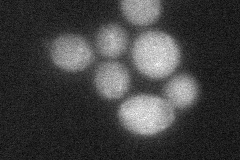
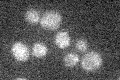

View description
Putative mitochondrial NAD+ transporter, member of the mitochondrial carrier subfamily (see also YIA6); has putative human ortholog
Localization:
Intensity:
Fold change:
Significance:
-
C’ GFP library in SD
mitochondria17.61 -
N' NOP1pr-GFP in SD
cytosol55.347 -
N' TEF2pr-mCherry in SD

cytosol85.2174 -
N' NATIVEpr-GFP in SD
below threshold29.1097 -
N' TEF2pr-VC and Cyto-VN in SD
cytosol33.3896 -
C’ GFP library in SD+DTT

mitochondria16.370.92No -
C’ GFP library in SD+H2O2

mitochondria17.841.01No -
C’ GFP library in Starvation Media
mitochondria16.670.94No -
C’ GFP library on the background of Pup2-DaMP

N/A -
C’ GFP library on the background of CCT mutant

N/A0N/AYes
